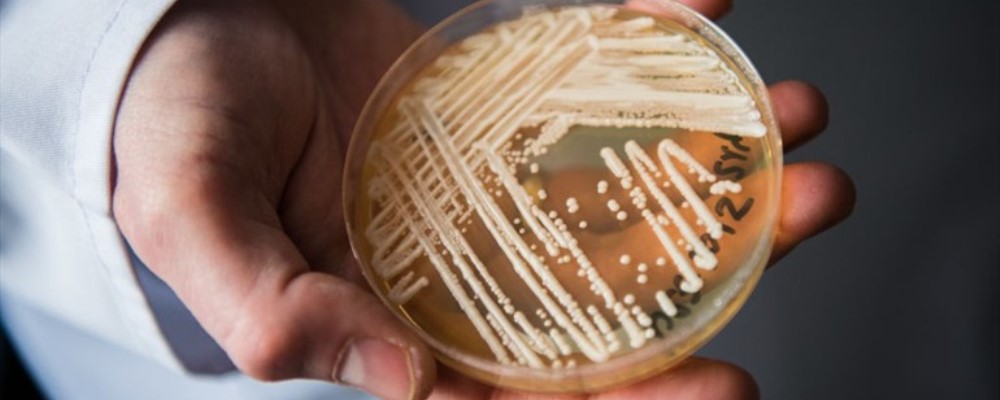

De momento, Chile se encuentra libre de este resistente patógeno.
Alerta ha generado la explosiva aparición de infecciones por un hongo que se ha expandido rápidamente a nivel mundial en los últimos meses.
Se trata del Candida auris, una especie que afecta el torrente sanguíneo, el sistema respiratorio, la orina y heridas previas en pacientes hospitalizados que poseen su sistema inmune debilitado.
Según recopiló The New York Times, se han multiplicado en países como España, Venezuela, Reino Unido, India, Pakistán, Colombia, Israel, Sudáfrica y Estados Unidos.
Precisamente en este último se han detectado más de 550 casos confirmados y el Centro para el Control y la Prevención de Enfermedades (CDC, por sus siglas en inglés) sumó a este hongo a la lista de «amenazas urgentes» para la salud global.
De momento, Chile y el resto de Sudamérica aparecen libres de este patógeno, excepto por Venezuela y Colombia.
Sin embargo, la comunidad científica se ha mostrado preocupada porque la Candida auris es difícil de erradicar. En el 90% de los casos, la infección del hongo se ha mostrado resistente al menos a un fármaco, mientras que el 30% lo han hecho con uno o dos medicamentos.